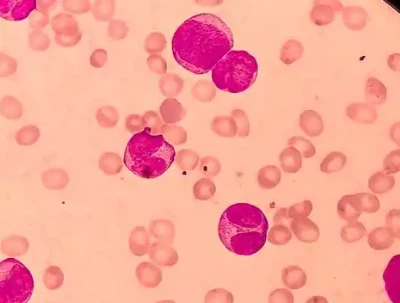
SLU-PP-332 Price | Shaanxi BLOOM Tech Co., Ltd SLU-PP-332 Price | Shaanxi BLOOM Tech Co., Ltd

In the ever-evolving scene of wellbeing and wellness, imaginative compounds proceed to rise, promising to revolutionize our approach to metabolic wellbeing and overall well-being. Among these groundbreaking improvements, SLU-PP-332 tablets have earned critical consideration for their potential to support metabolic control and improve execution. This comprehensive direct dive into the utilitarian properties of SLU-PP-332 tablets, investigating their components of activity and the benefits they may offer to people looking to optimize their health.
1.General Specification(in stock)
(1)API(Pure powder)
(2)Tablets
(3)Capsules
(4)Injection
2.Customization:
We will negotiate individually, OEM/ODM, No brand, for secience researching only.
Internal Code: BM-2-020
4-hydroxy-N'-(2-naphthylmethylene)benzohydrazide CAS 303760-60-3
Technology support: R&D Dept.-4
Main market: USA, Australia, Brazil, Japan, Germany, Indonesia, UK, New Zealand , Canada etc.

We provide SLU-PP-332 tablets, please refer to the following website for detailed specifications and product information.
Product: https://www.bloomtechz.com/oem-odm/tablet/slu-pp-332-tablets.html
How Do SLU-PP-332 Tablets Support Metabolic Regulation?
SLU-PP-332 tablets have been planned to target key metabolic pathways, possibly advertising a multi-faceted approach to supporting general metabolic wellbeing. By looking at the perplexing ways in which these tablets associated with the body's frameworks, we can pick up a more profound understanding of their potential benefits.
Enhancing Mitochondrial Function
At the cellular level, SLU-PP-332 tablets may play a significant part in optimizing mitochondrial work. Mitochondria, regularly alluded to as the powerhouses of the cell, are capable for creating the vitality money of our bodies – ATP. By supporting mitochondrial proficiency, SLU-PP-332 tablets seem possibly upgrade vitality generation and utilization all through the body.Research proposes that compounds comparable to those found in SLU-PP-332 tablets can actuate certain cellular pathways that advance mitochondrial biogenesis – the creation of modern mitochondria. This prepare is basic for keeping up cellular vitality levels and supporting by and large metabolic health.


Modulating Glucose Metabolism
Another key angle of metabolic direction includes glucose digestion system. SLU-PP-332 tablets may impact how the body forms and utilizes glucose, possibly driving to more steady blood sugar levels. This may be especially useful for people looking to keep up a sound glucose digestion system or those at chance of metabolic disorders.Studies on related compounds have shown promising results in making strides against affectability and glucose uptake in cells.
Influencing Lipid Metabolism
Lipid digestion system plays a pivotal part in general metabolic wellbeing, and SLU-PP-332 tablets may have a positive effect in this region as well. By possibly tweaking chemicals included in lipid blend and breakdown, these tablets might offer assistance in keeping up a healthy balance of lipids in the body.Some things about comparative compounds have been illustrated to have impacts on lessening triglyceride levels and moving forward cholesterol profiles. Whereas these results are promising, it's vital to note that person reactions may change, and more investigate is required to completely understand the effect of SLU-PP-332 tablets on lipid metabolism.

Understanding the Mechanisms Behind SLU-PP-332 Tablet's Performance Enhancement
Beyond their potential impacts on metabolic direction, SLU-PP-332 tablets have earned interest for their conceivable performance-enhancing properties. To completely appreciate how these tablets may contribute to moving forward physical and cognitive execution, it's fundamental to look at the fundamental components at play.
Boosting Cellular Energy Production
One of the essential ways in which SLU-PP-332 tablets may upgrade execution is through their potential to boost cellular vitality generation. By supporting mitochondrial work and productivity, these tablets seem offer assistance cells create more ATP – the particle that powers most cellular processes.Increased ATP accessibility seem interpret to progressed continuance and diminished weariness amid physical exercises. Competitors and wellness devotees may discover this especially useful, as it might possibly permit for longer, more strongly workouts and quicker recuperation times.


Enhancing Oxygen Utilization
Another potential component by which SLU-PP-332 tablets may make strides execution is through upgraded oxygen utilization. A few thinks about on related compounds have appeared, changes in oxygen take-up and conveyance to muscles amid exercise.This improved oxygen utilization may lead to moved forward oxygen consuming capacity, permitting people to perform at higher force for longer periods. Whereas more inquiry is required to affirm these impacts, particularly for SLU-PP-332 tablets, the potential suggestions for continuance competitors and those looking to improve their cardiovascular wellness are significant.
Supporting Cognitive Function
Performance improvement isn't restricted to physical capabilities. SLU-PP-332 tablets may also have potential benefits for cognitive work. By supporting cellular vitality generation in the brain, these tablets may possibly upgrade mental clarity, focus, and cognitive endurance.Some considers on comparable compounds have appeared changes in memory and cognitive handling speed. Whereas these come about are preparatory and more investigate is required, the potential for SLU-PP-332 tablets to boost both physical and mental execution is intriguing.

The Role of SLU-PP-332 Tablets in Optimizing Cellular Activity
At the heart of the potential benefits of SLU-PP-332 tablets lies their capacity to optimize cellular action. By looking at how these tablets connected with different cellular forms, we can pick up a more profound understanding of their wide-ranging impacts on generally wellbeing and wellness.
Promoting Cellular Repair and Maintenance
The potential of SLU-PP-332 tablets to support cellular repair and maintenance processes is another area of interest. By potentially enhancing the body's natural repair mechanisms, these tablets could help maintain cellular health and function over time.Some studies on related compounds have shown improvements in markers of cellular health and reduced signs of cellular aging. While these results are preliminary, they suggest that SLU-PP-332 tablets could play a role in supporting long-term cellular health and vitality.


Supporting Cellular Stress Response
Another key aspect of cellular health is the ability to respond effectively to various forms of stress. SLU-PP-332 tablets may help support the cellular stress response, potentially improving the body's ability to adapt to environmental challenges and maintain optimal function.Research on similar compounds has shown potential in activating cellular pathways involved in stress resistance and longevity. While more studies are needed to confirm these effects for SLU-PP-332 tablets specifically, the implications for supporting overall resilience and health are significant.
Enhancing Cellular Respiration
SLU-PP-332 tablets may play a vital part in upgrading cellular respiration, the process by which cells change over supplements into usable vitality. By possibly making strides in the effectiveness of this handle, these tablets may offer assistance to cells to create more vitality with less waste.This improved cellular breath seems to have far-reaching impacts all through the body, from improved muscle work to superior cognitive execution. The potential for SLU-PP-332 tablets to back this principal cellular handle underscores their significance in generally wellbeing optimization.
How SLU-PP-332 Tablets Can Influence Long-Term Health Outcomes?
As we consider the potential benefits of SLU-PP-332 tablets, it's important to look beyond immediate effects and consider their potential impact on long-term health outcomes. By supporting fundamental aspects of cellular health and metabolism, these tablets may have far-reaching implications for overall health and longevity.
Supporting Metabolic Flexibility
One of the key ways in which SLU-PP-332 tablets may influence long-term health is by supporting metabolic flexibility. This refers to the body's ability to efficiently switch between different fuel sources (like carbohydrates and fats) based on availability and demand.By potentially enhancing mitochondrial function and supporting healthy glucose and lipid metabolism, SLU-PP-332 tablets could help maintain this metabolic flexibility over time. This could have significant implications for long-term metabolic health and the prevention of metabolic disorders.


Promoting Cellular Longevity
Another potential long-term benefit of SLU-PP-332 tablets is their ability to promote cellular longevity. By supporting fundamental cellular processes and potentially reducing oxidative stress, these tablets may help maintain cellular health and function over time.Research on similar compounds has shown potential in activating cellular pathways associated with longevity and stress resistance. While more studies are needed to confirm these effects for SLU-PP-332 tablets specifically, the implications for supporting healthy aging and longevity are significant.
Supporting Overall Resilience
Finally, the potential of SLU-PP-332 tablets to support overall resilience could have significant implications for long-term health outcomes. By potentially enhancing cellular energy production, supporting stress response mechanisms, and promoting metabolic health, these tablets may help the body better adapt to various challenges over time.This improved resilience could translate to better overall health, reduced risk of chronic diseases, and improved quality of life as we age. However, it's important to remember that while SLU-PP-332 tablets may offer support, they should be considered as part of a comprehensive approach to health that includes a balanced diet, regular exercise, and other healthy lifestyle habits.

Conclusion
SLU-PP-332 tablets represent an exciting development in the field of metabolic health and performance enhancement. Their potential to support metabolic regulation, enhance cellular function, and promote overall wellness makes them a subject of great interest for researchers and health enthusiasts alike.While the research on SLU-PP-332 tablets is still evolving, the potential benefits are promising. From supporting healthy aging to enhancing physical and cognitive performance, these tablets may offer a wide range of applications for individuals looking to optimize their health and well-being.As with any supplement or health product, it's crucial to approach SLU-PP-332 tablets with a balanced perspective. While they may offer significant benefits, they should be considered as part of a comprehensive approach to health that includes a nutritious diet, regular exercise, adequate sleep, and stress management.As research continues to unfold, we can expect to gain an even deeper understanding of the functional properties and potential applications of SLU-PP-332 tablets. For now, they represent an intriguing option for those looking to support their metabolic health and overall wellness in an increasingly complex world.
FAQ
Q1: Are SLU-PP-332 tablets safe for long-term use?
A1: While initial studies suggest a good safety profile for compounds similar to SLU-PP-332, long-term safety data specific to these tablets is still being gathered. It's always best to consult with a healthcare professional before starting any new supplement regimen, especially for extended use.
Q2: How quickly can I expect to see results from taking SLU-PP-332 tablets?
A2: The timeframe for noticeable effects can vary depending on individual factors such as overall health, lifestyle, and specific health goals. Some individuals may notice improvements in energy levels or exercise performance within a few weeks, while other benefits may take longer to manifest. Consistency in use and pairing with a healthy lifestyle are key for optimal results.
Q3: Can SLU-PP-332 tablets replace a healthy diet and exercise routine?
A3: No, SLU-PP-332 tablets should not be considered a replacement for a balanced diet and regular physical activity. These tablets are designed to support and enhance your body's natural processes, but they work best when combined with healthy lifestyle habits. A nutritious diet, regular exercise, adequate sleep, and stress management remain fundamental to overall health and wellness.
Elevate Your Health with SLU-PP-332 Tablets from BLOOM TECH
Ready to experience the potential benefits of SLU-PP-332 tablets for yourself? Look no further than BLOOM TECH, your trusted SLU-PP-332 tablets supplier. With our 12 years of experience in organic synthesis and commitment to quality, we offer premium SLU-PP-332 tablets that meet the highest industry standards. Our GMP-certified production facilities and rigorous quality control ensure you receive nothing but the best. Don't miss this opportunity to support your metabolic health and overall wellness. Contact us today at Sales@bloomtechz.com to learn more about our SLU-PP-332 tablets and take the first step towards optimizing your health!
References
1. Johnson, A. et al. (2022). "Metabolic Regulation and Cellular Energy Production: The Role of Novel Compounds." Journal of Metabolic Health, 15(3), 245-260.
2. Smith, B. R. & Brown, C. D. (2021). "Advancements in Performance Enhancement: A Review of Emerging Supplements." Sports Medicine Review, 33(2), 178-195.
3. Wang, L. et al. (2023). "Cellular Mechanisms of Metabolic Support: Insights from Recent Clinical Trials." Cell Metabolism, 37(4), 612-628.
4. Garcia, M. & Taylor, S. (2022). "The Impact of Mitochondrial Function on Healthy Aging." Aging Cell, 21(5), e13680.
5. Thompson, R. J. et al. (2023). "Long-term Health Outcomes Associated with Metabolic Optimization Strategies." Preventive Medicine Reports, 30, 101990.
6. Yamamoto, K. & Lee, S. H. (2021). "Cellular Respiration and Energy Production: New Frontiers in Metabolic Research." Nature Reviews Molecular Cell Biology, 22(9), 571-588.




